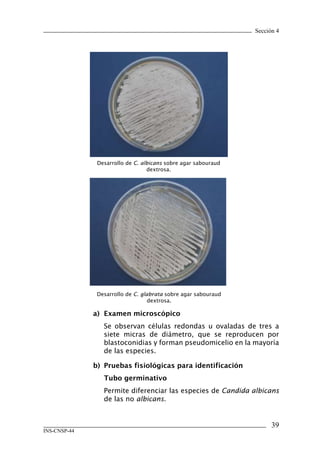
Sección 4




               Desarrollo de C. albicans sobre agar sabouraud
                                  dextrosa.




               Desarrollo de C. glabrata sobre agar sabouraud
                                   dextrosa.

              a)	 Examen	microscópico
                 Se observan células redondas u ovaladas de tres a
                 siete micras de diámetro, que se reproducen por
                 blastoconidias y forman pseudomicelio en la mayoría
                 de las especies.

              b)	 Pruebas	fisiológicas	para	identificación
                 Tubo	germinativo
                 Permite diferenciar las especies de Candida albicans
                 de las no albicans.


                                                                      3
INS-CNSP-44
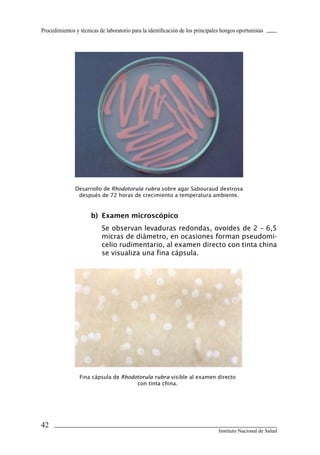
Procedimientos y técnicas de laboratorio para la identificación de los principales hongos oportunistas




               Desarrollo de Rhodotorula rubra sobre agar Sabouraud dextrosa
                después de 72 horas de crecimiento a temperatura ambiente.


                      b)	 Examen	microscópico
                           Se observan levaduras redondas, ovoides de 2 – 6,5
                           micras de diámetro, en ocasiones forman pseudomi-
                           celio rudimentario, al examen directo con tinta china
                           se visualiza una fina cápsula.




                 Fina cápsula de Rhodotorula rubra visible al examen directo
                                      con tinta china.




42
                                                                                 Instituto Nacional de Salud
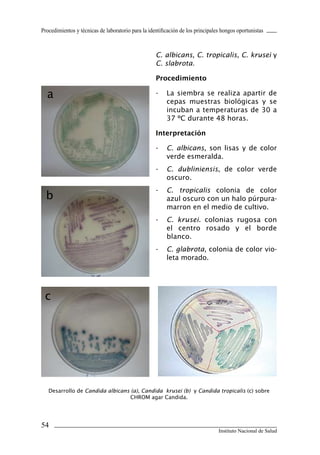
Procedimientos y técnicas de laboratorio para la identificación de los principales hongos oportunistas



                                                    C. albicans, C. tropicalis, C. krusei y
                                                    C. slabrota.

                                                    Procedimiento

  a                                                 -    La siembra se realiza apartir de
                                                         cepas muestras biológicas y se
                                                         incuban a temperaturas de 30 a
                                                         37 ºC durante 48 horas.

                                                    Interpretación

                                                    -    C. albicans, son lisas y de color
                                                         verde esmeralda.
                                                    -    C. dubliniensis, de color verde
                                                         oscuro.
                                                    -    C. tropicalis colonia de color
  b                                                      azul oscuro con un halo púrpura-
                                                         marron en el medio de cultivo.
                                                    -    C. krusei. colonias rugosa con
                                                         el centro rosado y el borde
                                                         blanco.
                                                    -    C. glabrota, colonia de color vio-
                                                         leta morado.




 c




   Desarrollo de Candida albicans (a), Candida krusei (b) y Candida tropicalis (c) sobre
                                  CHROM agar Candida.




54
                                                                                 Instituto Nacional de Salud

Este documento presenta un manual de procedimientos y técnicas de laboratorio para la identificación de los principales hongos oportunistas causantes de micosis humanas. El manual describe los procedimientos para la obtención, transporte y conservación de muestras clínicas, así como los procedimientos para el diagnóstico micólogico mediante examen directo y cultivo. Además, proporciona las técnicas para la identificación de las principales levaduras y hongos filamentosos de importancia en salud pública.












![Sección 1
y profundas. Lima: Instituto Nacional de Salud; 1997.
Serie de Normas Técnicas N.º 23.
1.3.16. Hoog GS, Guarro J, Gené J, Figueras MJ. Atlas clinical of
fungi. 2nd ed. Reus: Universitat Rovira I Virgili; 2000.
1.3.17. San Juan R, Berenguer J, Aguado JM. Hongos filamentosos
emergentes: Scedosporium [documento en internet].
España; 2004. Disponible en: www.seimc.org/control/
revi_Mico/pdf/Honemerg.pdf
1.3.18. Crespo V, Ojeda A, Vera A, Crespo A, Sánchez F.
Aislamiento e identificación de Malassezia spp. en
pitiriasis versicolor, dermatitis seborreica y piel sana.
Rev Iberoam Micol 199; 16: 16-21.
1.3.19. Giusiano GE. Malassezia. Estado del conocimiento y
perspectivas en su estudio. Rev Argent Microbiol 2006;
38(1): 41-48.
1.3.20. Guillot J, Guého E, Lesourd M, Midgley G, Chévrier
G, Dupont B. Identification of Malassezia species. A
practical approach. J. Mycol Med 1996; 6: 103-10.
1.3.21. Guého E, Midgley G, Guillot J. 1996. The genus
Malassezia with description of four new species. Antonie
van Leeuwenhoek 1995; 69: 337-55.
1.3.22. Haley L, Callaway C. Laboratory methods in medical
mycology. Atlanta: U.S. Department of Heath, Education
and Welfare. Public Health Service. CDC; 1978.
1.3.23. Bodey G. Candidiasis. Pathogenesis, diagnosis, and
treatment. 2nd ed. New York: Raven Press; 1993.
1.3.24. Laszlo A, Weyer K, Barrera L, Balandrano S, Ridderhof
J, Smithwick R, et al. Baciloscopía directa de BAAR. Un
programa de capacitación para laboratorios. Atlanta:
OMS/UICTER/CDC/OPS/INDRE/APHL; 2000.
1.3.25. Canelo C. Determinación de las variedades neoformans
y gattii en cepas de Cryptococcus de origen clínico
conservadas en el Instituto Nacional de Salud. [Tesis
para optar el titulo profesional de biólogo con mención
en microbiología y parasitología]. Lima: Universidad
Nacional Mayor de San Marcos; 1999.
11
INS-CNSP-44](https://image.slidesharecdn.com/10171006-katherinevasquezflechas-120219123422-phpapp02/85/10171006-katherine-vasquez-flechas-13-320.jpg)